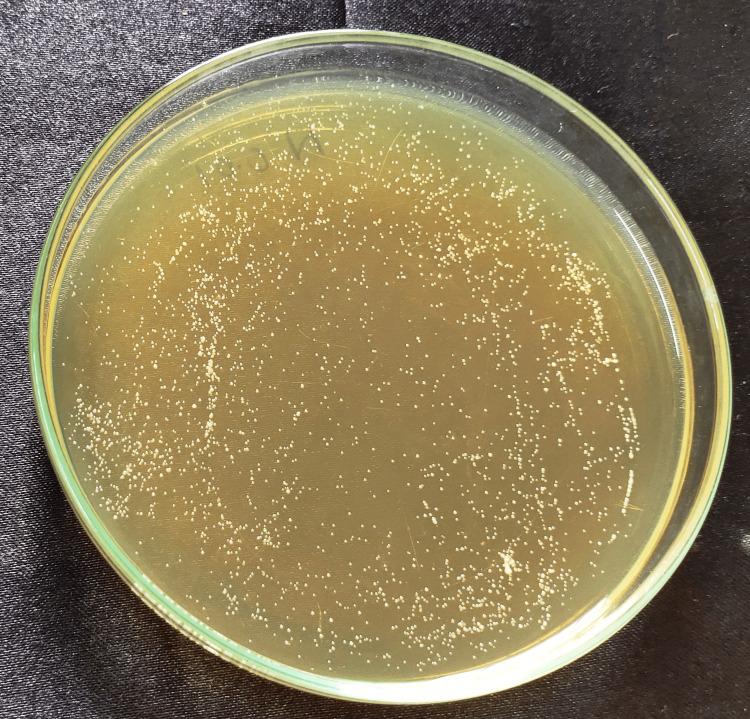
https://cdn.ncbi.nlm.nih.gov/pmc/blobs/1a96/10695085/f3d7b130c3c1/cureus-0015-00000048260-i08.jpg
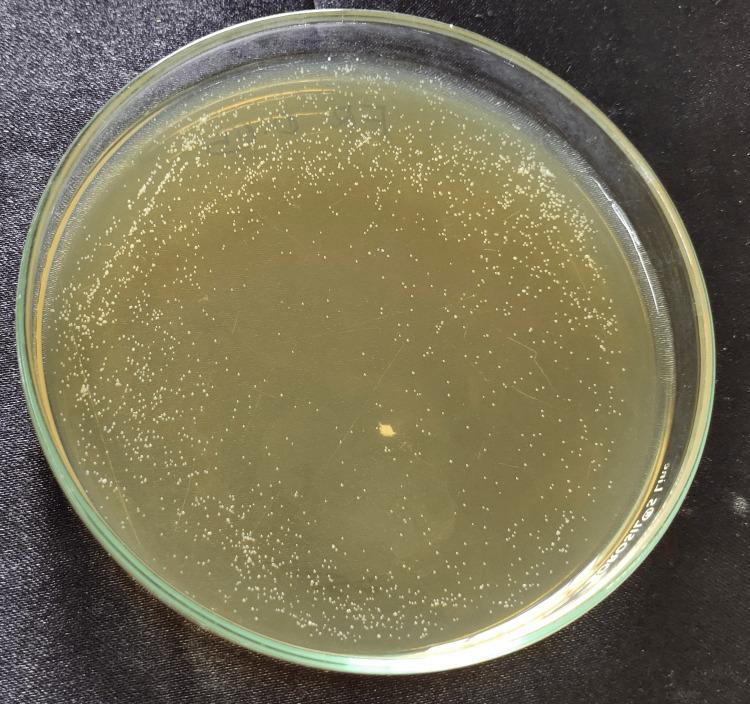
https://cdn.ncbi.nlm.nih.gov/pmc/blobs/1a96/10695085/d4129f28ae41/cureus-0015-00000048260-i06.jpg
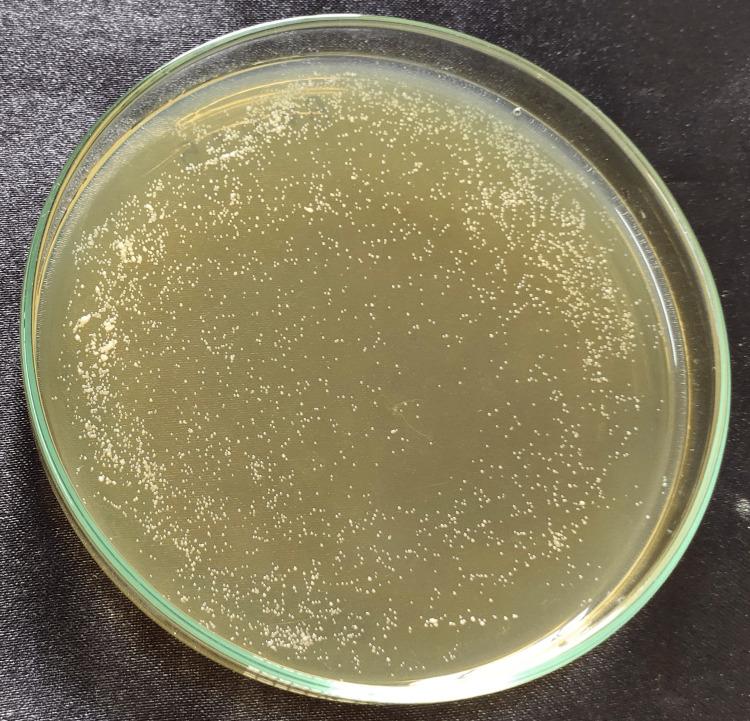
https://cdn.ncbi.nlm.nih.gov/pmc/blobs/1a96/10695085/b9ac1db5c327/cureus-0015-00000048260-i04.jpg
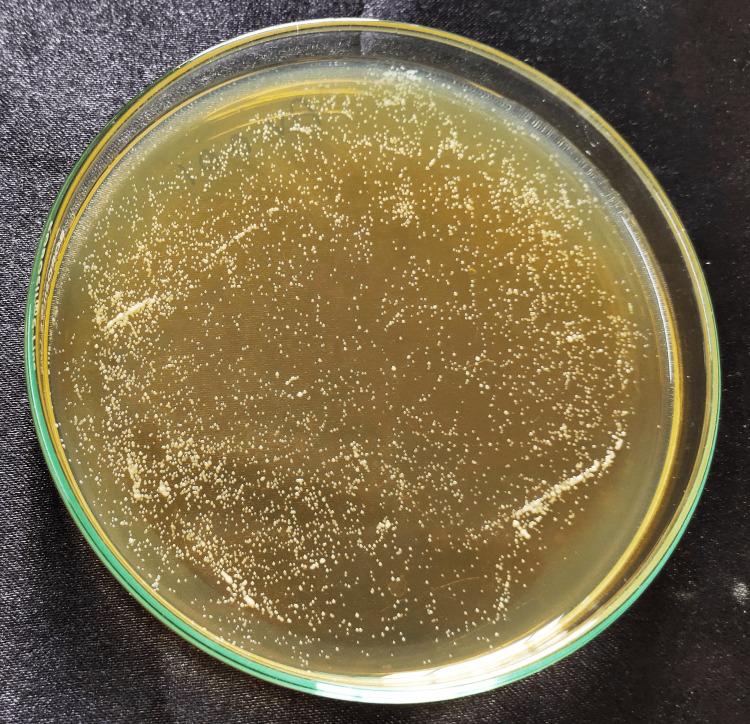
https://cdn.ncbi.nlm.nih.gov/pmc/blobs/1a96/10695085/76c700c3c99a/cureus-0015-00000048260-i03.jpg
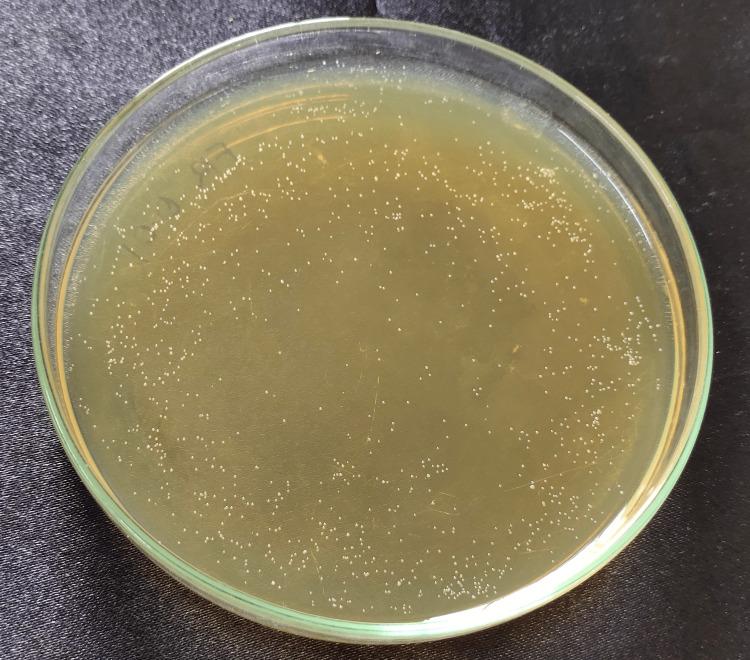
https://cdn.ncbi.nlm.nih.gov/pmc/blobs/1a96/10695085/5a96b92478a3/cureus-0015-00000048260-i09.jpg

含库拉索芦荟、海巴戟和圆叶砂仁银纳米颗粒的义齿基托树脂物理性能评估及其抗菌效果:一项体外研究
Evaluation of Physical Properties of Denture Base Resins Containing Silver Nanoparticles of Aloe barbadensis Miller, Morinda citrifolia, and Boesenbergia rotunda and Its Anti-microbial Effect: An In Vitro Study.
作者信息
Kaul Saguna, Ahmed Shafath, Nandini Vidyashree V, Lathief Jailance, Boruah Shiney
机构信息
Prosthodontics, Sri Ramaswamy Memorial (SRM) Kattankulathur Dental College, Chennai, IND.
出版信息
Cureus. 2023 Nov 4;15(11):e48260. doi: 10.7759/cureus.48260. eCollection 2023 Nov.
Introduction The denture bases fabricated from polymethylmethacrylate (PMMA) have some disadvantages, such as surface prone to microbial growth and biofilm accumulation, which contributes to the onset and dissemination of infections among denture wearers. Therefore, the purpose of this in vitro study was to evaluate the flexural strength, hardness, and antimicrobial effect of denture base resin incorporated with 0.05% and 0.1% silver nanoparticles (AgNPs) of Aloe barbadensis miller (aloe vera), Morinda citrifolia (noni), and Boesenbergia rotunda (finger root). Materials and methods A total of 84 PMMA samples were used and were divided into three groups. Flexural strength tests were performed on Group 1 PMMA blocks. Group 2 involved hardness testing of PMMA blocks, whereas Group 3 involved antimicrobial activity. Each group was subsequently split into seven subgroups with differing concentrations of AgNPs: Sub Group 1: control (no AgNPs), Sub Group 2: 0.05% aloe vera AgNPs, Sub Group 3: 0.1% aloe vera AgNPs, Sub Group 4: 0.05% noni AgNPs, Sub Group 5: 0.1% of noni AgNPs, Sub Group 6: 0.05% finger root AgNPs, and Sub Group 7: 0.1% finger root AgNPs. The flexural strength was evaluated using a universal testing machine (Instron 8801). Surface hardness was measured using a Vickers tester (Tukon 1102). For the antimicrobial activity analysis, the samples were incubated in a suitable culture broth containing Candida albicans for 24 hours. Microbial colony count (colony-forming unit (CFU)/mL) was estimated to evaluate the microbial adhesion to the surface of the denture base materials. Statistical analysis The flexural strength, hardness, and CFU between the groups were analyzed using one-way analysis of variance (ANOVA) followed by multiple comparisons with Tukey's honest significant difference (HSD) test (α=0.05). The level of statistical significance was determined at p<0.05. Results It was observed that the mean flexural strength was maximum in PMMA incorporated with 0.05% of aloe vera AgNPs and least in PMMA incorporated with 0.1% noni AgNPs. It was seen that a steady loss in flexural strength is observed from 0.05% to 0.1%. The mean hardness was maximum in PMMA incorporated with 0.1% of noni AgNPs and least in PMMA incorporated with 0.05% aloe vera AgNPs. It was also found that the hardness was directly proportional to the number of nanoparticles. With an increase in the weight percentage of nanoparticles, a steady increase in hardness was seen in all the test groups. In our study, the results showed that finger root 0.1% showed the least CFU with a significant reduction of C. albicans adherence; therefore, it indicates higher anti-fungal activity. Aloe vera 0.05% showed the lowest inhibition of C. albicans, suggesting the least anti-fungal activity. Conclusion Within the limitations of this study, It can thus be concluded that the addition of AgNPs incorporated with plant extracts of Aloe barbadensis miller (aloe vera), Morinda citrifolia (noni), and Boesenbergia rotunda (finger root) can alter the flexural strength, hardness, and microbial adhesion of PMMA. In our study, it can be concluded that flexural strength increases with the addition of AgNPs of 0.5% concentration after which a steady loss is seen. However, the hardness and antimicrobial activity increased with an increase in the concentration of AgNPs in all three plant extracts.
引言 由聚甲基丙烯酸甲酯(PMMA)制成的义齿基托存在一些缺点,例如表面易于微生物生长和生物膜积聚,这会导致义齿佩戴者发生感染并传播。因此,本体外研究的目的是评估掺入0.05%和0.1%库拉索芦荟(芦荟)、海巴戟(诺丽果)和圆叶砂仁(手指姜)银纳米颗粒(AgNPs)的义齿基托树脂的弯曲强度、硬度和抗菌效果。
材料和方法 总共使用了84个PMMA样品,并将其分为三组。对第1组PMMA块进行弯曲强度测试。第2组涉及PMMA块的硬度测试,而第3组涉及抗菌活性测试。随后,每组又分为七个含有不同浓度AgNPs的亚组:亚组1:对照组(无AgNPs),亚组2:0.05%芦荟AgNPs,亚组3:0.1%芦荟AgNPs,亚组4:0.05%诺丽果AgNPs,亚组5:0.1%诺丽果AgNPs,亚组6:0.05%手指姜AgNPs,亚组7:0.1%手指姜AgNPs。使用万能材料试验机(Instron 8801)评估弯曲强度。使用维氏硬度计(Tukon 1102)测量表面硬度。对于抗菌活性分析,将样品在含有白色念珠菌的合适培养液中孵育24小时。估计微生物菌落计数(菌落形成单位(CFU)/mL)以评估微生物对义齿基托材料表面的粘附。
统计分析 使用单因素方差分析(ANOVA)分析各组之间的弯曲强度、硬度和CFU,随后使用Tukey诚实显著差异(HSD)检验进行多重比较(α=0.05)。统计显著性水平确定为p<0.05。
结果 观察到,掺入0.05%芦荟AgNPs的PMMA的平均弯曲强度最大,而掺入0.1%诺丽果AgNPs的PMMA的平均弯曲强度最小。可以看出,从0.05%到0.1%,弯曲强度稳步下降。掺入0.1%诺丽果AgNPs的PMMA的平均硬度最大,而掺入0.05%芦荟AgNPs的PMMA的平均硬度最小。还发现硬度与纳米颗粒的数量成正比。随着纳米颗粒重量百分比的增加,所有测试组的硬度都稳步增加。在我们的研究中,结果表明0.1%手指姜组的CFU最少,白色念珠菌的粘附显著减少;因此,它表明具有更高的抗真菌活性。0.05%芦荟组对白色念珠菌的抑制作用最低,表明抗真菌活性最低。
结论 在本研究的局限性内,可以得出结论,掺入库拉索芦荟(芦荟)、海巴戟(诺丽果)和圆叶砂仁(手指姜)植物提取物的AgNPs可以改变PMMA的弯曲强度、硬度和微生物粘附。在我们的研究中,可以得出结论,添加0.5%浓度的AgNPs后弯曲强度增加,此后会稳步下降。然而,在所有三种植物提取物中,硬度和抗菌活性都随着AgNPs浓度的增加而增加。